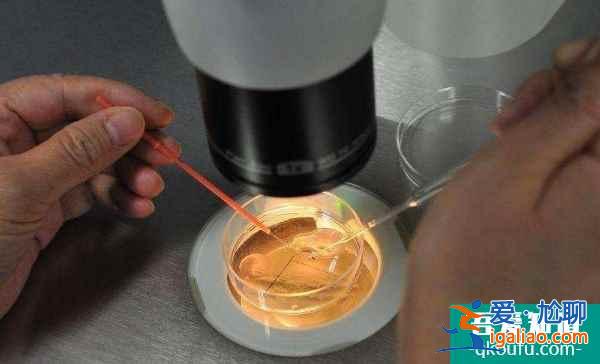
試管嬰兒如何提高卵子受精率?? 試管嬰兒如何提高卵子受精率??

試管嬰兒如何提高卵子受精率??
在備受業內人士和難孕家庭推崇和好評的EDEN生殖醫院,專家們遵循科學安全的助孕原則,堅持健康優生的醫療實踐理念,從實際出發,為每一位客戶制定專屬合適的診療方案,利用先進的試管技術幫助解決生育問題,實現寶寶夢想,讓家庭完整。對此,有嘉賓問:在美國做試管嬰兒如何提高卵子受精率?
試管嬰兒如何提高卵子受精率?

EDEN專家表示,卵子和精子是生命的根源。如果精卵質量差,活力低,染色體異常或畸形,或者卵子不成熟,很有可能受精不成功,從而影響試管成功率。所以,在美國做試管嬰兒,提高卵子受精率的關鍵是獲得優質健康的卵子和精子,然后專家可以利用先進的精子注射技術(ICSI)顯著提高受精率,幫助順利完成試管診療周期,獲得健康的孩子,實現生育夢想。具體來說,以下詳細分析:
1、提高精卵質量

去美國做試管前,EDEN專家建議夫妻雙方要照顧好自己,提高卵子和精子的質量,為試管打下堅實的基礎。比如在飲食方面,我們要有健康的飲食和均衡的營養。可以多吃抗氧化水果(如草莓、藍莓),高蛋白、高纖維、易消化的食物,補充多種維生素;減少或不喝含咖啡因的飲料,戒煙戒酒;同時女性每天可服用400-600mg輔酶Q10,延緩卵巢衰老,提高卵子質量;男性可以服用南寶膠囊,提高精子活力,降低精子破碎率,提高精子質量。
此外,我們應該堅持鍛煉,每天進行半小時以上的有氧運動,如慢跑和游泳。并且避免熬夜,保持充足的睡眠;調整心態,減少壓力,保持愉快的心情,為試管嬰兒加分。
2、科學促排和精子洗滌

科學促排卵,獲得優質成熟卵子:進入試管周期后,EDEN專家會根據女性的實際情況(年齡、卵巢功能和基礎卵泡數量等)制定合適的促排卵方案。),通過合理用藥促進排卵,用藥期間進行實時跟蹤監測,結合女性對藥物的反應進行調整,從而促進卵巢內多個卵泡發育至成熟,提高卵子產量,幫助獲得優質成熟卵子,為試管后續環節打下良好基礎。

精子洗滌:為保證精子質量,EDEN專家將采用全新的Perecoll梯度離心洗精技術,對提取的精液進行優化洗滌,可去除死精子、炎性精子、精子抗體、炎性細胞等不利受精的成分,再通過高速顯微鏡從中挑選形態正常、活力強的精子。
3、單精子注射-提高受精率
在獲得優質精子和卵子的基礎上,EDEN專家利用單精子注射技術(ICSI)直接將優質精子注入卵子,提高受精率。專家表示,這項技術跨越了精子運動、頂體反應釋放頂體酶、顆粒細胞消化、精卵結合、透明帶反應等一系列步驟。并能顯著提高卵子受精率,目前已達到99%以上。
建議EDEN醫院的ICSI技術由有經驗的生殖專家在擁有高端設備的胚胎實驗室進行(實驗室配備了包括ICSI設備在內的高端醫療設備和儀器,可以為精子注射提供有利保障),這樣手術更精準,成功率更高。
專家表示,第二代試管嬰兒精子注射技術(ICSI)的研發和臨床應用,標志著人類輔助生殖技術進入了一個新的階段,如今經過幾十年的成熟發展,已經取得了長足的進步。試管嬰兒專家在顯微操作系統的幫助下,將單個精子注射到卵子中使其受精,可以大大提高卵子的受精率,進而提高試管嬰兒的成功率。
先進<愛尬聊_創建詞條>試管技術-助健康優生,圓生育之夢!
致力于為客戶提供先進的輔助生殖技術和高質量的醫療服務,擁有世界一流的醫療設備和高素質的生殖專家。他們通過多年豐富的診療經驗,為有生育需求的客戶開發專屬適用的試管項目,應用先進技術幫助解決生育問題,幫助健康優生。

在試管周期中,為了保證胚胎的健康,提高著床率和妊娠質量,EDEN專家在單精子注射后第5天將受精卵放入專門研制的優質培養基中,形成結構穩定、活力強、活性強的優質囊胚(臨床研究表明,囊胚更符合子宮的生理狀態,著床后能與子宮內膜同步,因此移植成功率更高)。
之后,EDEN專家使用了PGS/PGD基因檢測技術
術對囊胚的23對染色體進行篩查診斷,對比分析囊胚是否存在染色體異常(缺失、倒置、易位、重復等)的情況,或是對基因突變點進行檢測,診斷是否攜帶遺傳缺陷的基因或可能導致特定致病基因突變,再擇優挑選健康的囊胚植入女性的子宮內,從根源上保障寶寶的健康,實現優生優育。EDEN伊甸園醫院作為輔助生殖行業的標桿,專家在多年的醫療實踐中形成了套獨特完整且行之有效的診療體系和方法,會根據每位客戶的實際情況為之制定專屬的診療方案,并且在整個試管診療周期中,專家會嚴格把控每項助孕環節,專業規范操作,為您試管診療周期保駕護航,幫助顯著提高卵子受精率,助早日完成生育夢想,綻放生命之美!
